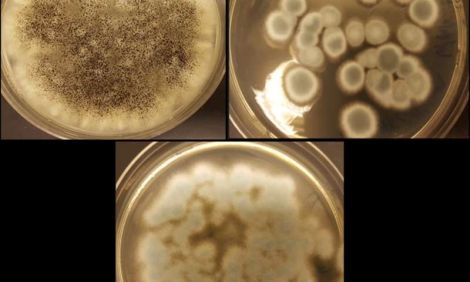

Hiện có nhiều phương pháp để tách lithium, coban và các kim loại khác, nhưng chúng đòi hỏi nhiệt độ cao và hóa chất mạnh. Trong nghiên cứu này, các nhà khoa học đã áp dụng một phương pháp an toàn cho môi trường dựa vào nấm có trong tự nhiên.
Để thực hiện quy trình tái chế, nhóm nghiên cứu sử dụng ba chủng nấm - Aspergillus niger, Penicillium simplicissimum và Penicillium chrysogenum. "Chúng tôi đã lựa chọn các chủng nấm này vì chúng được quan sát thấy có hiệu quả chiết tách kim loại từ các loại chất thải khác" TS. Jeffrey A. Cunningham, trưởng nhóm nghiên cứu nói. "Chúng tôi cho rằng các cơ chế chiết tách đều như nhau và như vậy, các loại nấm này chắc chắn có thể hoạt động để khai thác lithium và cobalt từ pin đã qua sử dụng”.
Đầu tiên, các nhà khoa học tháo dỡ pin và nghiền cực âm thành bột. Sau đó, họ cho bột cực âm tiếp xúc với nấm. "Nấm tự nhiên tạo ra các axit hữu cơ và các axit này hoạt động để lọc kim loại", TS. Cunningham giải thích. "Thông qua các tương tác giữa nấm, axit và cực âm đã nghiền thành bột, chúng tôi có thể chiết tách coban và lithium giá trị. Chúng tôi đang đặt mục tiêu thu hồi gần như toàn bộ vật liệu ban đầu".
Kết quả nghiên cứu cho thấy việc sử dụng axit oxalic và axit xitric, hai trong số các axit hữu cơ do nấm sản sinh, có thể chiết tách đến 85% lithium và 48% coban từ cực âm của pin đã qua sử dụng. Nhưng, axit gluconic không có hiệu quả chiết tách kim loại.
Tuy nhiên, sau khi tiếp xúc với nấm, coban và lithium vẫn ở trong môi trường axit lỏng. Do vậy, vấn đề trọng tâm hiện nay là làm thế nào để thu hồi 2 nguyên tố này từ chất lỏng.
Các nhà nghiên cứu khác cũng đang sử dụng nấm để chiết tách kim loại từ chất thải điện tử, nhưng TS. Cunningham tin rằng chỉ có nhóm của ông nghiên cứu phương pháp lọc sinh học bằng nấm để tách kim loại từ pin sạc thải loại. Nhóm nghiên cứu hiện đang tìm kiếm các chủng nấm khác nhau, các axit mà nấm sản sinh và hiệu quả của axit trong việc khai thác kim loại trong những môi trường khác nhau.

Về trang trước
Về trang trước Về đầu trang
Về đầu trang


















